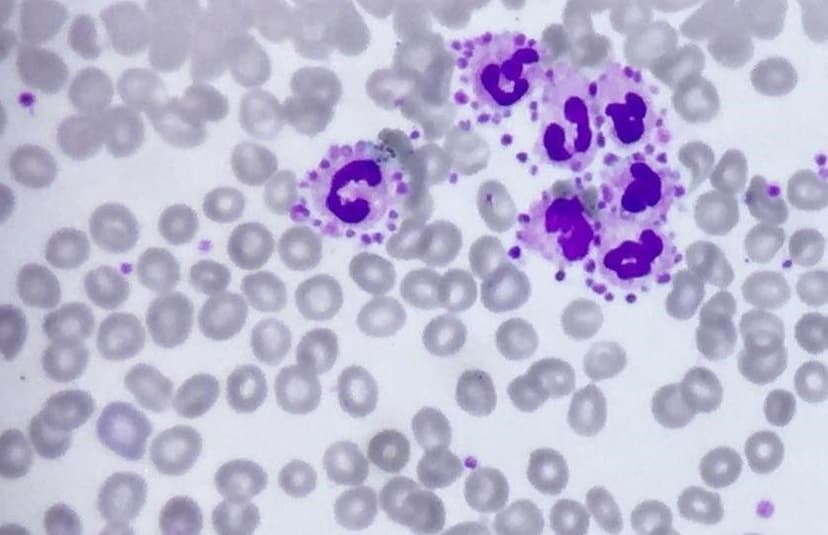
پدیده تجمع اقماری پلاکت‌ها در اطراف لکوسیت‌های نوتروفیل
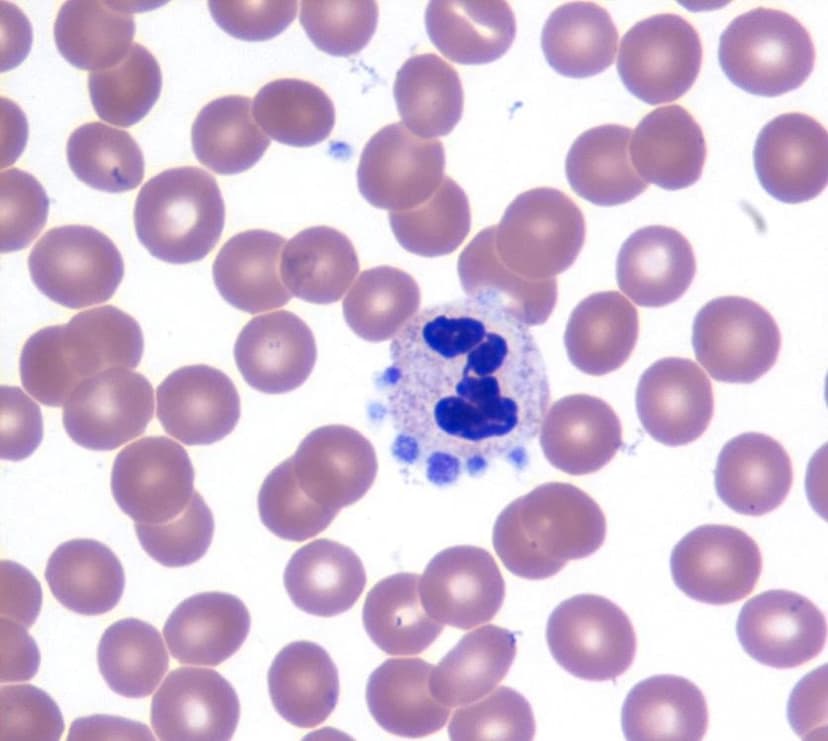
پدیده تجمع اقماری پلاکت‌ها در اطراف لکوسیت‌های نوتروفیل
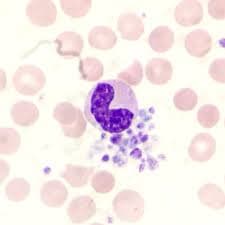
پدیده تجمع اقماری پلاکت‌ها در اطراف لکوسیت‌های نوتروفیل
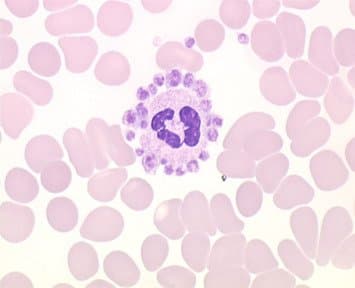
پدیده تجمع اقماری پلاکت‌ها در اطراف لکوسیت‌های نوتروفیل
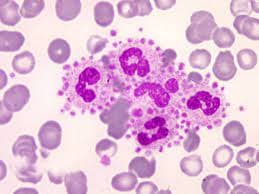
پدیده تجمع اقماری پلاکت‌ها در اطراف لکوسیت‌های نوتروفیل

پدیده تجمع اقماری پلاکتها در اطراف لکوسیتهای نوتروفیل
یک پدیده ناشایع آزمایشگاهی (in vitro) و بدون اهمیت بالینی است، به این معنی که ارتباط سببی با بیماری خاصی ندارد و علت آن میتواند ایمیونولوژیک یا غیرایمیونولوژیک باشد، البته بصورت بسیار نادر به همراه برخی اختلالات هماتولوژیک (مانند آنمیهمولیتیک اتوایمیون یا سندرومهای میلودیسپلاستیک) ممکن است دیده شود. این پدیده بصورت تجمع پلاکتها در اطراف لکوسیتهای نوتروفیلی مشاهده میشود و نمائی مشابه گل رز را به نمایش میگذارد و در نمونههای خون محیطی که با استفاده از ماده ضد انعقاد اتیلندیآمینتترااستیکاسید (EDTA) تهیه شده، با فراوانی حدود 8 هزارم درصد (0.008%) رخ میدهد، در موارد نادری ممکن است تجمع پلاکتها در اطراف سایر لکوسیتهای خونی نیز مشاهده شود و از این جهت مهم است که موجب کاهش شمارش پلاکتها و بنابراین ترومبوسیتوپنی کاذب میگردد. برای رفع این اشکال لازم است نمونهگیری خون با استفاده از ماده ضدانعقاد سیترات سدیم (یا هپارین) تکرار شده و با استفاده از دستگاههای اتوماتیک شمارش پلاکتها انجام گیرد. اضافه کردن کانامایسین به میزان 20 میلیگرم درهرمیلیلیتر به ضد انعقاد EDTA باعث پراکنده شدن پلاکتها از اطراف نوتروفیلها میشود.